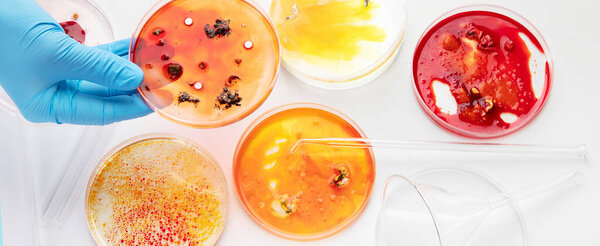
Фон с лабораторной чашкой Петри. Микробиология. Вид сверху.

- /
- Поиск /
- Комплект лабораторных материалов. Чашка Петри, кветт спектрофотометра
Комплект лабораторных материалов. Чашка Петри, кветт спектрофотометра
Комплект лабораторных материалов. Чашка Петри, кветы спектрофотометра, анализ крови, пробирка
,
image
image
May.28, 2013 07:19:49
30.66
0.96
478x500
956x1000
1912x2000
5414x5664
5414x5664
508
7
motorolka
КРАСНЫЙ БЕЛЫЙ КРУГЛЫЙ ФОН МАКРО НАБОР РОСТ ЖИДКОСТЬ МИКРО ЗДОРОВЬЕ ЖИЗНЬ ЕДА КРОВЬ МЕДИЦИНА ГРИБ BACKGROUND БИОЛОГИЧЕСКИЕ ТЕСТ ОРГАНИЧЕСКИЕ ТРУБКА БОЛЕЗНИ НЕЗДОРОВЫЕ БИОЛОГИЯ ЛАБОРАТОРИЯ ГРИБЫ РАСПРОСТРАНЕНИЕ ИССЛЕДОВАНИЕ АНАЛИЗ НАУЧНЫЙ МИКРОБ SPORE ДРОЖЖИ ГНИЛОЙ РАЗМНОЖЕНИЕ КОЛОНИЯ ПРОБИРКА АЛЛЕРГИЯ ИСПОРЧЕННЫЙ ПЛЕСЕНЬ ИНФЕКЦИЯ КОПИЧЕСКИЙ ПРОЛИФЕРАЦИЯ ПЕТРИ РЕПЛИКАЦИИ СПЕКТРОФОТОМЕТР МИКРОПРОБИРКА QUVETTES